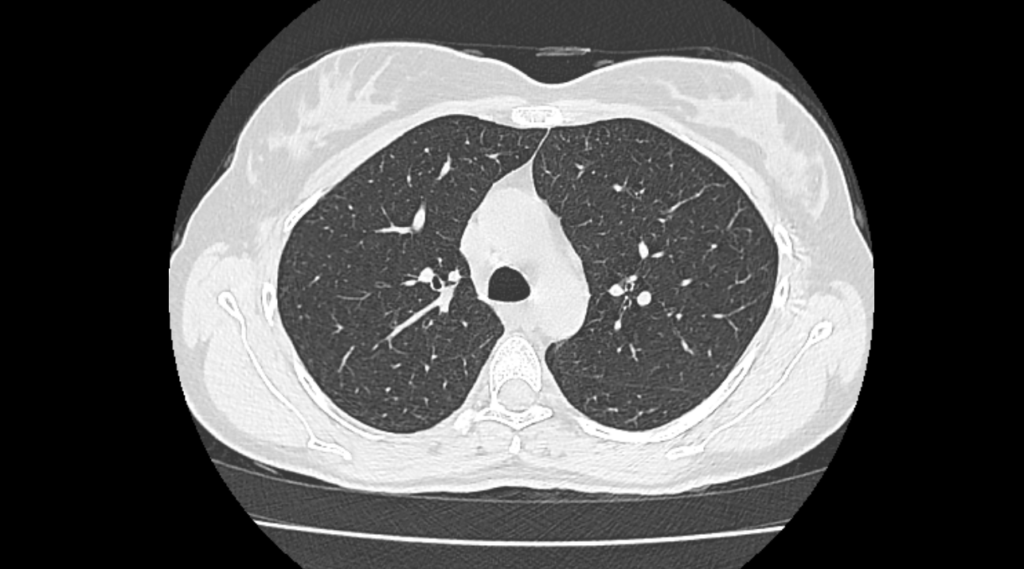
Medical Imaging

Precision in Every
Image & Diagnosis
Empowering healthcare providers with rapid, accurate, and secure remote radiology reporting services. 24/7 expert coverage for MRI, CT, X-Ray, and more.





Our Services
Comprehensive teleradiology solutions tailored to your needs.

MRI
MRI
CT Imaging
CT

X-Ray
X-RAY

Ultrasound
ULTRASOUND

Mammography
MAMMOGRAPHY

Cardiac CT
CARDIAC CT

CT Angiography
CT ANGIOGRAPHY

Bone Densitometry (BMD)
BMD

MR Angiography
MR ANGIOGRAPHY

PET CT
PET CT
Why Choose Global eTeleRad?
We combine cutting-edge technology with world-class medical expertise to deliver superior radiology services.
Support 24/7
Our 24/7 IT support continuously monitors systems to prevent delays, ensuring 99.8% uptime and seamless service reliability.
Sub-Specialty Experts
Access to a diverse team of fellowship-trained radiologists across all modalities.
Secure & Confidential
Patient data remains in a secure, HIPAA-compliant environment with top-tier encryption, redundant power, and 24/7 access control for maximum safety.
Quality Assurance
Rigorous double-blind peer review process maintaining a 99.9% accuracy rate.
Global Network
Seamless integration with hospitals and imaging centers worldwide.
What Our Clients Say
"Global eTeleRad has transformed our workflow. Their turnaround time for emergency cases is exceptional, and the report quality is consistently high."
Dr. Sarah Johnson
Chief of Radiology, City General Hospital
Join Our Team
Be part of a dynamic team revolutionizing teleradiology services. We're always looking for talented professionals.
Why Work With Us?
Join Global eTeleRad and contribute to improving healthcare delivery through cutting-edge teleradiology solutions. We offer competitive benefits and a collaborative work environment.
Open Positions
Radiologists, IT Specialists, Customer Support, and more
Professional Growth
Continuous learning opportunities and career advancement
Flexible Work
Remote opportunities and flexible scheduling available
Get in Touch
Ready to optimize your radiology workflow? Contact us today.
Contact Information
Reach out to us for any inquiries about our teleradiology services. We're here to help 24/7.
Phone
+971 56 510 0483Address
BC-378921, 26th Floor
Amber Gem Tower
Ajman, United Arab Emirates